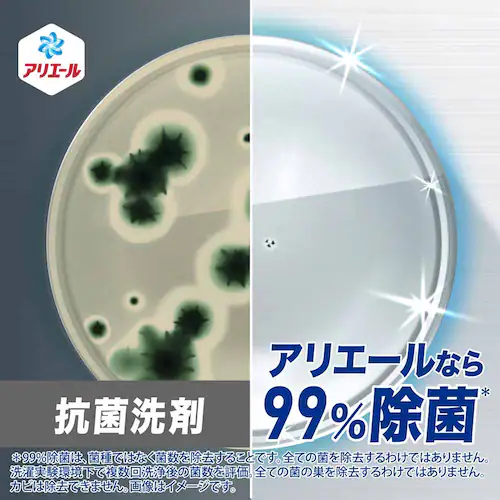
P&G アリエールジェル 洗濯槽まるごと除菌 超ウルトラジャンボ×2+ジェルボール部屋干し付バンドルパック 【プラザセレクト】_5

獲得予定ポイント
- 通常ポイント内訳
- お買い物ポイント
- 1倍
- 合計
- 29ポイント
※ポイントの獲得には会員ログインが必要です
商品をシェアする
4.67 3件
P&G アリエールジェル 洗濯槽まるごと除菌 超ウルトラジャンボ×2+ジェルボール部屋干し付バンドルパック
リンクをコピーしました。
P&G アリエールジェル 洗濯槽まるごと除菌 超ウルトラジャンボ×2+ジェルボール部屋干し付バンドルパック
1〜3日以内発送
- イチオシ
- ¥2,980(税込) 送料無料
- 29ポイント
- (1倍)
液体洗剤つめかえ用約2.3ヶ月分※×2 約4.6ヶ月分※ + 無料ジェルボールお試し7個入り
漂白剤つけ置きパワーin
※週に約4.7回、2.8kgを洗たく(本品35mL使用)の場合
漂白剤つけ置きパワーin
※週に約4.7回、2.8kgを洗たく(本品35mL使用)の場合
もっと見る
※製品は予告なく仕様を変更する場合がございます。あらかじめご了承ください。
●商品サイズ(cm)
幅約37×奥行約12×高さ約38
●商品重量
3440g+7個
●成分
ジェル:界面活性剤(33%:直鎖アルキルベンゼンスルホン酸塩、ポリオキシエチレンアルキルエーテル)、pH調整剤(クエン酸)、安定化剤、分散剤ジェルボール:界面活性剤(69%:アルキルエーテル硫酸エステル塩、ポリオキシエチレンアルキルエーテル、直鎖アルキルベンゼンスルホン酸塩、純せっけん分(脂肪酸塩))、安定化剤(プロピレングリコール)、香料、分散剤、水軟化剤、蛍光増白剤、酵素
| JAN |
4987176331595
|
|---|
※当商品はお取り寄せ品の為、在庫の確認及び商品のお届けまでお時間を頂く場合がございます。
また、商品がメーカーにて完売となっていた場合、キャンセル又は注文内容の変更をお願いいたしております。
予めご了承くださいますようお願いいたします。 ■こちらの商品はアイリスプラザがセレクトしたオススメ商品です。
(ご注意)
数量限定商品はご注文が完了しても完売になる場合がございます。ご注文をいただいた後にお断りさせていただく場合がございますのでなにとぞご了承ください。
また、商品がメーカーにて完売となっていた場合、キャンセル又は注文内容の変更をお願いいたしております。
予めご了承くださいますようお願いいたします。 ■こちらの商品はアイリスプラザがセレクトしたオススメ商品です。
(ご注意)
数量限定商品はご注文が完了しても完売になる場合がございます。ご注文をいただいた後にお断りさせていただく場合がございますのでなにとぞご了承ください。

※完売により、ご注文後にお断りする場合がございます。ご了承ください。